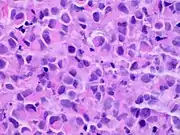

| Invasive lobular carcinoma | |
|---|---|
 | |
| Lobules of the mammary glands. | |
| Specialty | Oncology |

Invasive lobular carcinoma (ILC) is breast cancer arising from the lobules of the mammary glands.[1] It accounts for 5–10% of invasive breast cancer.[2][3] Rare cases of this carcinoma have been diagnosed in men (see male breast cancer).[4]
Types
| Classic lobular | Pleomorphic lobular | |
|---|---|---|
| Grades | Low or high (II/III) | High (III) |
| AJCC stage | I | II |
| Lymph node status | Negative | Positive |
| ER/PR status | Positive | Positive |
| Surgery type | Lumpectomy | Mastectomy |
The histologic patterns include:[6][7][8]
| Type | Prevalence | Description | Image |
|---|---|---|---|
| Classical | 40% | Round or ovoid cells with little cytoplasm in a single-file infiltrating pattern, sometimes concentrically giving a targetoid pattern | .jpg.webp) |
| Mixed | 40% | No dominant pattern | |
| Solid | 10% | Sheets of classical-appearing cells with little intervening stroma | |
| Alveolar | 5% | Aggregates of classical-appearing cells | |
| Tubulolobular | 5% | Cells form microtubules in >90% of tumor (smaller than in tubular carcinoma) | |
| Pleomorphic | Classical-appearing but with pleomorphic cells. It may include signet-ring cells, or plasmacytoid cells (pictured) which have abundant cytoplasm and eccentric nuclei. | |
 Histopathology of invasive lobular carcinoma (ILC), next to lobular carcinoma in situ (LCIS)
Histopathology of invasive lobular carcinoma (ILC), next to lobular carcinoma in situ (LCIS).jpg.webp) Invasive lobular carcinoma demonstrating a predominantly lobular growth pattern
Invasive lobular carcinoma demonstrating a predominantly lobular growth pattern Lobular breast cancer. Single file cells and cell nests.
Lobular breast cancer. Single file cells and cell nests.
Prognosis
Overall, the five-year survival rate of invasive lobular carcinoma was approximately 85% in 2003.[9]
Diagnosis
On mammography, ILC shows spiculated mass with ill-defined margins that has similar or lower density than surrounding breast tissues. This happens only at 44–65% of the time. Architectural distortion on surrounding breast tissues is only seen in 10–34% of the cases. It can be reported as benign in 8–16% of the mammography cases.[10]
Ultrasound has 68–98% sensitivity of detecting ILC. ILC shows irregular or angular mass with hypoechoic or heterogenous internal echoes, ill-defined or spiculated margins, and posterior acoustic shadowin.[10]
Loss of E-cadherin is common in lobular carcinoma but is also seen in other breast cancers.[11]
Treatment
Treatment includes surgery and adjuvant therapy.
References
- ↑ "Breast Cancer Treatment (PDQ®)". NCI. 23 May 2014. Archived from the original on 5 July 2014. Retrieved 29 June 2014.
- ↑ Pointon KS, Cunningham DA (August 1999). "Ultrasound findings in pure invasive lobular carcinoma of the breast: comparison with matched cases of invasive ductal carcinoma of the breast". Breast. 8 (4): 188–90. doi:10.1054/brst.1999.0042. PMID 14731438.
- ↑ Boughey JC, Wagner J, Garrett BJ, et al. (March 2009). "Neoadjuvant Chemotherapy in Invasive Lobular Carcinoma May Not Improve Rates of Breast Conservation". Ann. Surg. Oncol. 16 (6): 1606–11. doi:10.1245/s10434-009-0402-z. PMC 4338983. PMID 19280264.
- ↑ Nofal MN, Yousef AJ (December 2019). "The diagnosis of male breast cancer". The Netherlands Journal of Medicine. 77 (10): 356–359. PMID 31880271.
- ↑ Yang, Li-Peng; Sun, He-Fen; Zhao, Yang; Chen, Meng-Ting; Zhang, Nong; Jin, Wei (2017). "Clinicopathological characteristics and survival outcomes in pleomorphic lobular breast carcinoma of the breast: a SEER population-based study". Cancer Medicine. 6 (12): 2867–2875. doi:10.1002/cam4.1244. ISSN 2045-7634. PMC 5727339. PMID 29131529.
- ↑ Moore MM, Borossa G, Imbrie JZ, et al. (June 2000). "Association of Infiltrating Lobular Carcinoma With Positive Surgical Margins After Breast-Conservation Therapy". Ann. Surg. 231 (6): 877–82. doi:10.1097/00000658-200006000-00012. PMC 1421077. PMID 10816631.
- ↑ Spencer JT, Shutter J (March 2009). "Synchronous bilateral invasive lobular breast cancer presenting as carcinomatosis in a male". Am. J. Surg. Pathol. 33 (3): 470–4. doi:10.1097/PAS.0b013e318190d10d. PMID 19092630. S2CID 24935891.
- ↑ Fletcher's diagnostic histopathology of tumors. 3rd Ed. p. 931-932.
- ↑ Arpino G, Bardou VJ, Clark GM, Elledge RM (2004). "Infiltrating lobular carcinoma of the breast: tumor characteristics and clinical outcome". Breast Cancer Res. 6 (3): R149–56. doi:10.1186/bcr767. PMC 400666. PMID 15084238.
- 1 2 Lopez, January K.; Bassett, Lawrence W. (January 2009). "Invasive Lobular Carcinoma of the Breast: Spectrum of Mammographic, US, and MR Imaging Findings". RadioGraphics. 29 (1): 165–176. doi:10.1148/rg.291085100. ISSN 0271-5333. PMID 19168843.
- ↑ Varga Z, Mallon E (Oct 2009). "Histology and Immunophenotype of Invasive Lobular Breast Cancer. Daily Practice and Pitfalls" (PDF). Breast Dis. 30: 15–19. doi:10.3233/BD-2009-0278. PMID 19850991.